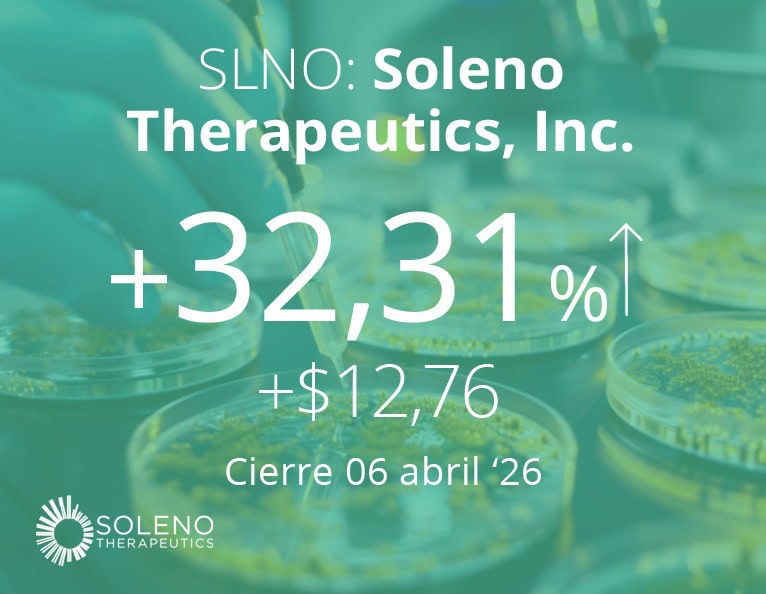

LA NOTICIA
Neurocrine Biosciences Inc. ($NBIX) y Soleno Therapeutics Inc. ($SLNO) anunciaron que Neurocrine ha celebrado un acuerdo definitivo para adquirir Soleno por $53 por acción en efectivo, lo que representa un valor patrimonial total de la transacción de $2.900M.
DAME CONTEXTO
La adquisición de Soleno y la incorporación de VYKAT XR (diazóxido de colina) una terapia "primera en su clase" para tratar la hiperfagia, la característica distintiva del síndrome de Prader-Willi (SPW), ampliarán la cartera de medicamentos innovadores de Neurocrine y fortalecerán su posición de liderazgo en endocrinología y enfermedades raras.
ENTONCES
Desde su aprobación por la FDA y su exitoso lanzamiento en EEUU durante el segundo trimestre de 2025, VYKAT XR ha demostrado una sólida adopción temprana, generando $190M en ingresos en 2025, incluyendo $92M para Soleno tan solo en el cuarto trimestre.
OTRA NOVEDAD
Con el respaldo de la infraestructura médica y comercial de Neurocrine, se espera que VYKAT XR continúe mejorando la atención a los pacientes con PWS, al tiempo que genere valor a largo plazo para los accionistas tras el cierre de la transacción.
PARA NO PERDER DE VISTA
El PWS es un trastorno genético raro del neurodesarrollo, causado por una anomalía en la expresión génica en el cromosoma 15, que afecta a cerca de 10.000 pacientes en EEUU. La enfermedad se caracteriza por disfunciones neurológicas, conductuales y metabólicas. Su rasgo distintivo es la hiperfagia, una afección crónica que pone en peligro la vida y que se caracteriza por un hambre persistente que impulsa una conducta compulsiva de búsqueda de alimentos.
POR ÚLTIMO
"Neurocrine es el socio estratégico idóneo para ampliar el alcance de VYKAT XR en la comunidad del síndrome de Prader-Willi, dada su experiencia en endocrinología y enfermedades raras, así como su capacidad demostrada para ejecutar lanzamientos comerciales exitosos", dijo Anish Bhatnagar, M.D., presidente del Consejo y Director Ejecutivo de Soleno.
![]()
Dato curioso
Un dedo tiene su propio pulso
Si alguna vez ha visto a alguien tomarse el pulso, habrá notado que los dedos índice y medio se presionan siempre sobre la arteria carótida del cuello, la cual se encarga de transportar la sangre hacia el cerebro. Existe una razón por la que los médicos utilizan estos dedos y no, por ejemplo, los pulgares. A diferencia de los otros cuatro dedos, el pulgar posee su propia arteria exclusiva, la princeps pollicis, lo que lo convierte en un instrumento biológicamente poco fiable para medir el pulso, ya que sentirá la pulsación de este dedo en lugar de la de la arteria del cuello.
Fuente: interestingfacts.com
![]()
|